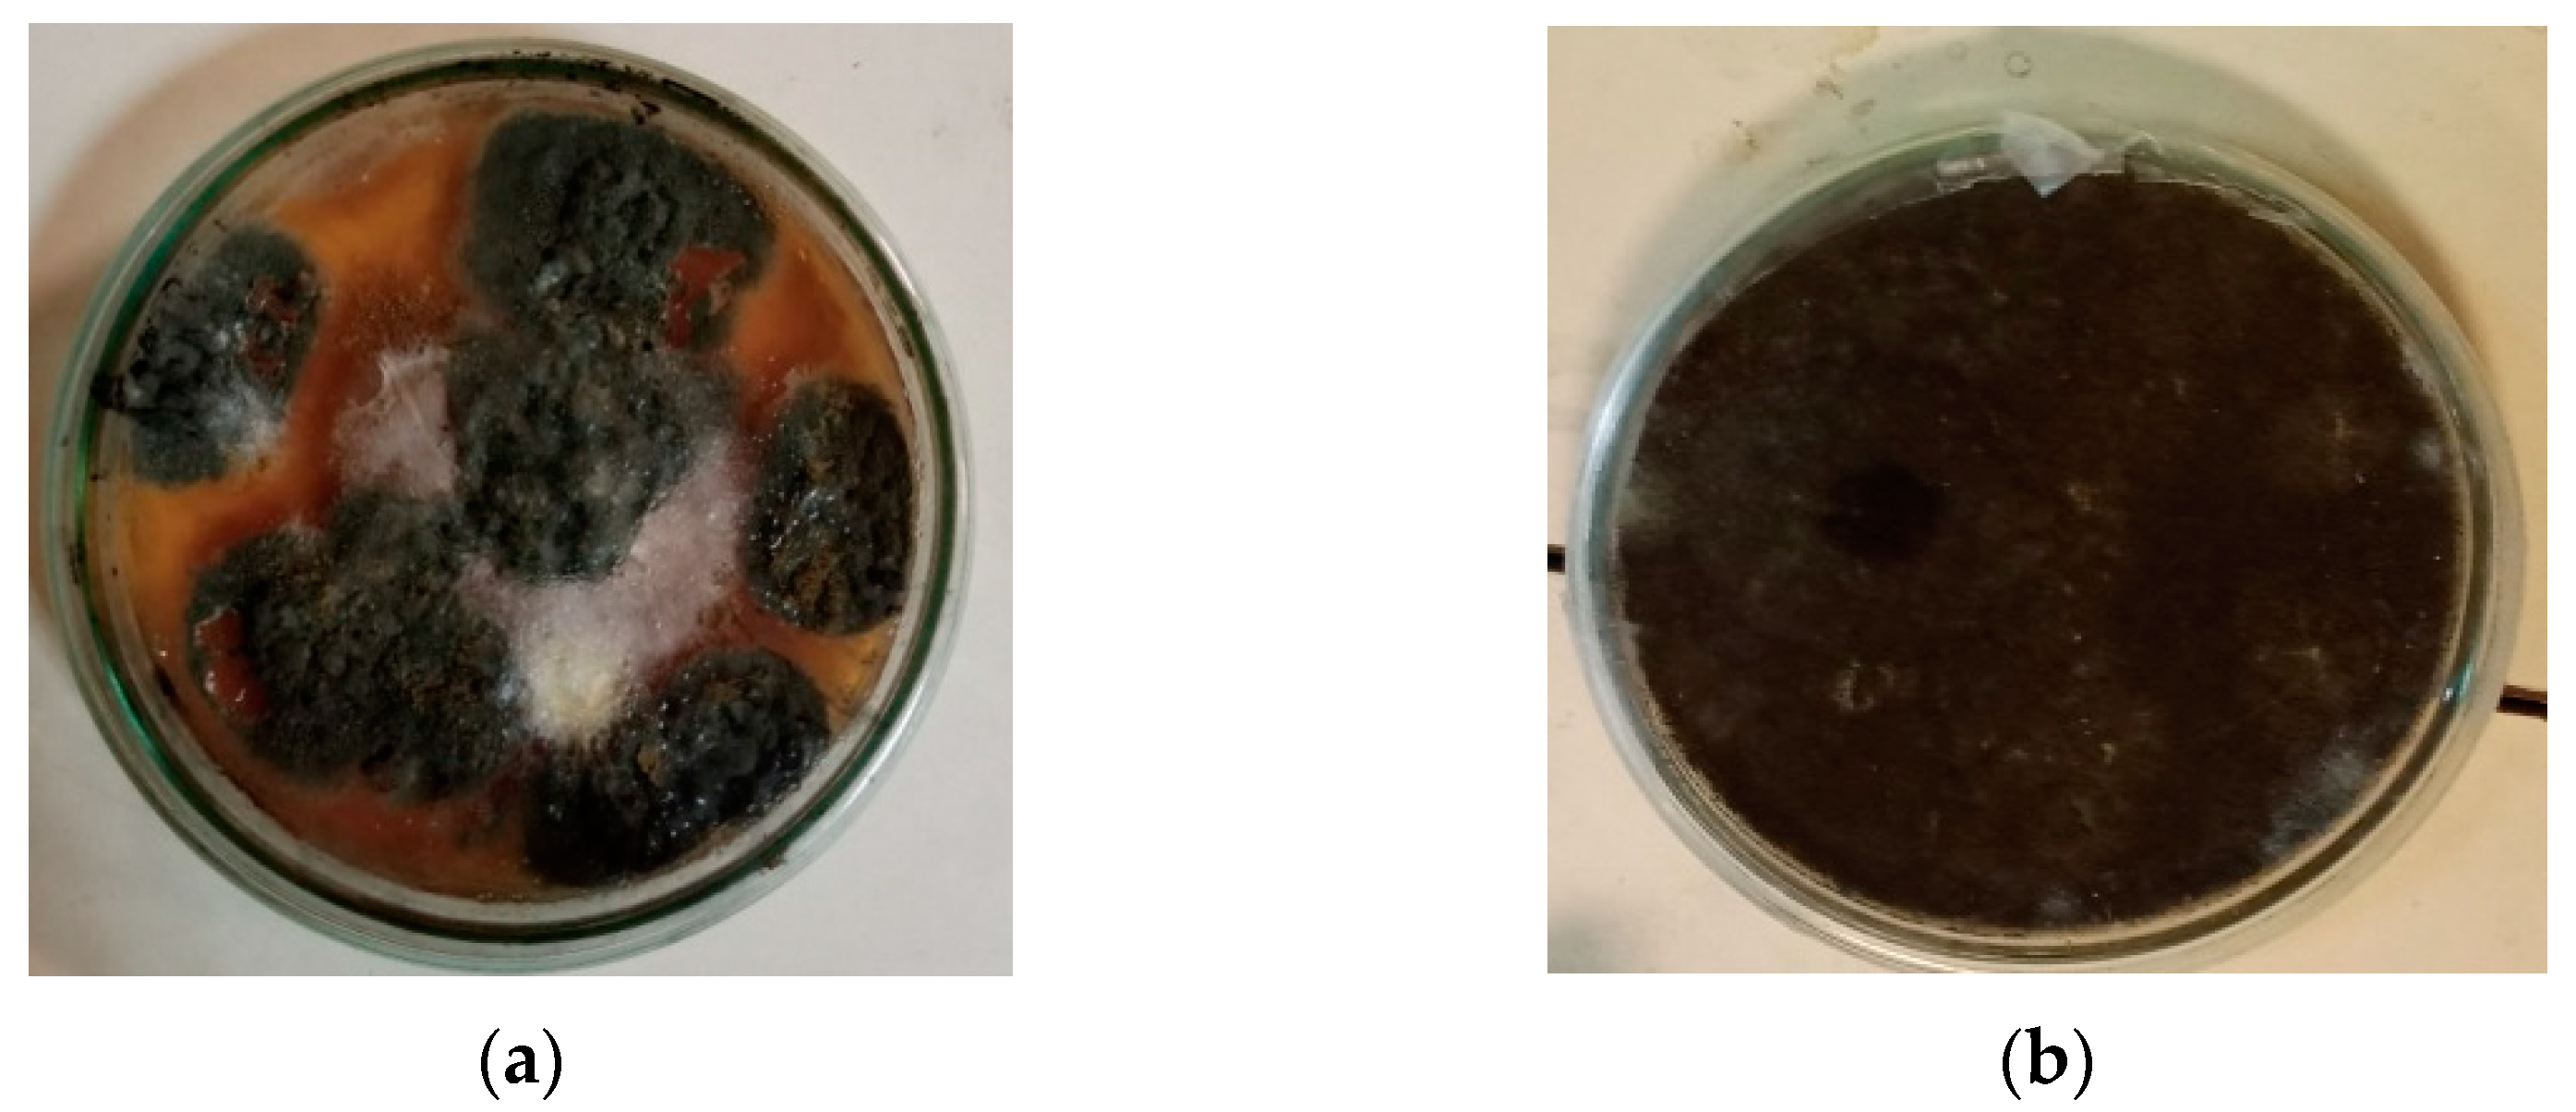
Polymers 17 01303 g002

Biodegradation Efficacy of Aspergillus niger and Trichoderma harzianum on Low-Density Polyethylene
Abstract
1. Introduction
2. Materials and Methods
2.1. Materials
2.2. Cultivation of Fungal Strains
2.3. Polyethylene Degradation Assay in Liquid Medium and Soil
2.4. Monitoring of Environmental Variables
2.5. Instrumental Analysis
3. Results
3.1. Polyethylene Degradation Assay by Weight Loss
3.2. Fourier Transform Infrared Spectroscopy
3.3. Thermogravimetric Analysis
3.4. Scanning Electron Microscopy
4. Discussion
5. Conclusions
Author Contributions
Funding
Institutional Review Board Statement
Data Availability Statement
Acknowledgments
Conflicts of Interest
References
- Statista. Annual Production of Plastics Worldwide from 1950 to 2023; Statista Research Department: New York, NY, USA, 2025; Available online: https://www.statista.com/statistics/282732/global-production-of-plastics-since-1950 (accessed on 15 March 2025).
- Statista. Global Plastics Waste Flow 2019; Statista Research Department: New York, NY, USA, 2023; Available online: https://www.statista.com/statistics/1357641/plastic-waste-lifecycle-worldwide (accessed on 15 March 2025).
- OECD. Policy Scenarios for Eliminating Plastic Pollution by 2040; OECD: Paris, France, 2024; Available online: https://www.oecd.org/en/publications/policy-scenarios-for-eliminating-plastic-pollution-by-2040_76400890-en.html (accessed on 15 March 2025).
- Dokl, M.; Copot, A.; Krajnc, D.; Fan, Y.V.; Vujanović, A.; Aviso, K.B.; Tan, R.R.; Kravanja, Z.; Čuček, L. Global projections of plastic use, end-of-life fate and potential changes in consumption, reduction, recycling and replacement with bioplastics to 2050. Sustain. Prod. Consum. 2024, 51, 498–518. [Google Scholar] [CrossRef]
- Aleksza, L. (Ed.) Waste Management; Profikomp Kft.: Gödöllő, Hungary, 2014; Available online: https://profikomp.com/waste-management-handbook (accessed on 15 March 2025).
- Loredo-Treviño, A.; Gutiérrez-Sánchez, G.; Rodríguez-Herrera, R.; Aguilar, C.N. Microbial enzymes involved in polyurethane biodegradation: A review. J. Polym. Environ. 2012, 20, 258–265. [Google Scholar] [CrossRef]
- Khan, A.K.; Majeed, T. Biodegradation of synthetic and natural plastics by microorganisms: A mini review. J. Nat. Appl. Sci. Pakistan 2019, 1, 180–184. [Google Scholar]
- Lin, S.; Wei, J.; Yang, B.; Zhang, M.; Zhuo, R. Bioremediation of organic pollutants by white rot fungal cytochrome P450: The role and mechanism of CYP450 in biodegradation. Chemosphere 2022, 301, 134776. [Google Scholar] [CrossRef]
- Chen, L.; Zhang, X.; Zhang, M.; Zhu, Y.; Zhuo, R. Removal of heavy-metal pollutants by white rot fungi: Mechanisms, achievements, and perspectives. J. Clean. Prod. 2022, 354, 131681. [Google Scholar] [CrossRef]
- Srikanth, M.; Sandeep, T.S.R.S.; Sucharitha, K.; Godi, S. Biodegradation of plastic polymers by fungi: A brief review. Bioresour. Bioprocess. 2022, 9, 42. [Google Scholar] [CrossRef]
- Varshney, S.; Gupta, V.; Yadav, A.N.; Rahi, R.K.; Devki, S.; Neelam, D.K. An overview on role of fungi in systematic plastic degradation. J. Appl. Biol. Biotechnol. 2023, 11, 61–69. [Google Scholar] [CrossRef]
- Ibrahim, S.S.; Ionescu, D.; Grossart, H.-P. Tapping into fungal potential: Biodegradation of plastic and rubber by potent Fungi. Sci. Total Environ. 2024, 934, 173188. [Google Scholar] [CrossRef] [PubMed]
- Khatua, S.; Simal-Gandara, J.; Acharya, K. Myco-remediation of plastic pollution: Current knowledge and future prospects. Biodegradation 2024, 35, 249–279. [Google Scholar] [CrossRef]
- Zeghal, E.; Vaksmaa, A.; Vielfaure, H.; Boekhout, T.; Niemann, H. The potential role of marine fungi in plastic degradation—A review. Front. Mar. Sci. 2021, 8, 738877. [Google Scholar] [CrossRef]
- Kim, S.H.; Lee, J.W.; Kim, J.S.; Lee, W.; Park, M.S.; Lim, Y.W. Plastic-inhabiting fungi in marine environments and PCL degradation activity. Antonie van Leeuwenhoek 2022, 115, 1379–1392. [Google Scholar] [CrossRef] [PubMed]
- Vaksmaa, A.; Vielfaure, H.; Polerecky, L.; Kienhuis, M.V.M.; van der Meer, M.T.J.; Pflüger, T.; Egger, M.; Niemann, H. Biodegradation of polyethylene by the marine fungus Parengyodontium album. Sci. Total Environ. 2024, 934, 172819. [Google Scholar] [CrossRef] [PubMed]
- Sen, S.K.; Raut, S. Microbial degradation of low density polyethylene (LDPE): A review. J. Environ. Chem. Eng. 2015, 3, 462–473. [Google Scholar] [CrossRef]
- Temporiti, M.E.E.; Nicola, L.; Nielsen, E.; Tosi, S. Fungal enzymes involved in plastics biodegradation. Microorganisms 2022, 10, 1180. [Google Scholar] [CrossRef]
- Das, M.P.; Kumar, S. Microbial deterioration of low-density polyethylene by Aspergillus and Fusarium sp. Int. J. ChemTech Res. 2014, 6, 299–305. [Google Scholar]
- Restrepo-Flórez, J.M.; Bassi, A.; Thompson, M.R. Microbial degradation and deterioration of polyethylene—A review. Int. Biodeterior. Biodegrad. 2014, 88, 83–90. [Google Scholar] [CrossRef]
- Rani, A.; Singh, P.; Kumar, R. Microbial deterioration of high-density polyethylene by selected microorganisms. J. Appl. Biol. Biotechnol. 2020, 8, 64–66. [Google Scholar] [CrossRef]
- Ghatge, S.; Yang, Y.; Ahn, J.-H.; Hur, H.-G. Biodegradation of polyethylene: A brief review. Appl. Biol. Chem. 2020, 63, 27. [Google Scholar] [CrossRef]
- Spina, F.; Tummino, M.L.; Poli, A.; Prigione, V.; Ilieva, V.; Cocconcelli, P.; Puglisi, E.; Bracco, P.; Zanetti, M.; Varese, G.C. Low density polyethylene degradation by filamentous fungi. Environ. Pollut. 2021, 274, 116548. [Google Scholar] [CrossRef]
- Esmaeili, A.; Pourbabaee, A.A.; Alikhani, H.A.; Shabani, F.; Esmaeili, E. Biodegradation of low-density polyethylene (LDPE) by mixed culture of Lysinibacillus xylanilyticus and Aspergillus niger in soil. PLoS ONE 2013, 8, e71720. [Google Scholar] [CrossRef]
- Gajendiran, A.; Krishnamoorthy, S.; Abraham, J. Microbial degradation of low-density polyethylene (LDPE) by Aspergillus clavatus strain JASK1 isolated from landfill soil. 3 Biotech 2016, 6, 52. [Google Scholar] [CrossRef] [PubMed]
- Munir, E.; Harefa, R.S.M.; Priyani, N.; Suryanto, D. Plastic degrading fungi Trichoderma viride and Aspergillus nomius found in Indonesia. J. Phys. Conf. Ser. 2018, 953, 012025. [Google Scholar] [CrossRef]
- Sáenz, M.; Borodulina, T.; Diaz, L.; Banchon, C. Minimal conditions to degrade low-density polyethylene by Aspergillus terreus and Aspergillus niger. J. Ecol. Eng. 2019, 20, 44–51. [Google Scholar] [CrossRef] [PubMed]
- Muhonja, C.N.; Makonde, H.; Magoma, G.; Imbuga, M. Biodegradability of polyethylene by bacteria and fungi from Dandora dumpsite Nairobi-Kenya. PLoS ONE 2018, 13, e0198446. [Google Scholar] [CrossRef]
- Kunlere, I.O.; Fagade, O.E.; Nwadike, B.I. Biodegradation of low-density polyethylene (LDPE) by certain indigenous bacteria and fungi. Int. J. Environ. Stud. 2019, 76, 428–440. [Google Scholar] [CrossRef]
- DSouza, G.C.; Sheriff, R.S.; Ullanat, V.; Shrikrishna, A.; Joshi, A.V.; Hiremath, L.; Entoori, K. Fungal biodegradation of low-density polyethylene using consortium of Aspergillus species under controlled conditions. Heliyon 2021, 7, e07008. [Google Scholar] [CrossRef]
- Khruengsai, S.; Sripahco, T.; Pripdeevech, P. Low-density polyethylene film biodegradation potential by fungal species from Thailand. J. Fungi 2021, 7, 594. [Google Scholar] [CrossRef]
- Siregar, R.M.; Yusuf, M.; Nufajriani; Dari, N.; Siregar, R.; Rahmah, M.; Nasution, M.H.; Widodo, P.A. Biodegradation study of LDPE/PCL polyblend plastic film by using the fungus Aspergillus niger. AIP Conf. Proc. 2022, 2659, 080007. [Google Scholar] [CrossRef]
- Saira, A.; Maroof, L.; Iqbal, M.; Farman, S.; Lubna, L.; Faisal, S. Biodegradation of low-density polyethylene (LDPE) bags by fungi isolated from waste disposal soil. Appl. Environ. Soil Sci. 2022, 2022, 8286344. [Google Scholar] [CrossRef]
- Safdar, A.; Ismail, F.; Iftikhar, H.; Khokhar, A.M.; Javed, A.; Imran, M.; Safdar, B. Determination of biodegradation potential of Aspergillus niger, Candida albicans, and Acremonium sclerotigenum on polyethylene, polyethylene terephthalate, and polystyrene microplastics. Int. J. Microbiol. 2024, 2024, 7682762. [Google Scholar] [CrossRef]
- Sutkar, P.R.; Hadkar, S.S.; Kamble, S.A.; Dhulap, V.P. Biodegradation potential of low-density polyethylene (LDPE) using Aspergillus niger and Phanerochaete chrysosporium. Discover Environ. 2025, 3, 7. [Google Scholar] [CrossRef]
- Sowmya, H.V.; Ramalingappa, B.; Krishnappa, M.; Thippeswamy, B. Degradation of polyethylene by Trichoderma harzianum—SEM, FTIR, and NMR analyses. Environ. Monit. Assess. 2014, 186, 6577–6586. [Google Scholar] [CrossRef] [PubMed]
- Johnnie, D.A.; Issac, R.; Prabha, M.L. Bio efficacy assay of laccase isolated and characterized from Trichoderma viride in biodegradation of low density polyethylene (LDPE) and textile industrial effluent dyes. J. Pure Appl. Microbiol. 2021, 15, 410–420. [Google Scholar] [CrossRef]
- Ruan, Y.; Hu, F.; Zhao, J.; Li, Y.; Ling, J.; Cao, J.; Zhang, L. Degradation of polyethylene particles by Trichoderma harzianum and recombinant laccase cloned from the strain. J. Appl. Polym. 2023, 140, 354599. [Google Scholar] [CrossRef]
- Bernat, P.; Jasińska, A.; Niedziałkowska, K.; Słaba, M.; Rózalska, S.; Paraszkiewicz, K.; Sas-Paszt, L.; Heipieper, H.J. Adaptation of the metolachlor-degrading fungus Trichoderma harzianum to the simultaneous presence of low-density polyethylene (LDPE) microplastics. Ecotoxicol. Environ. Saf. 2023, 267, 115656. [Google Scholar] [CrossRef]
- Zhu, L.; Chen, Y.; Ni, W.; Zeng, J.; Li1, X.; Hu, C.; Li, L. The degradation of polyethylene by Trichoderma and its impact on soil organic carbon. Agriculture 2024, 14, 1821. [Google Scholar] [CrossRef]
- Yang, W.K.; Gong, Z.; Wang, B.T.; Hu, S.; Zhuo, Y.; Jin, C.-Z.; Jin, L.; Lee, H.-G.; Jin, F.-J. Biodegradation of low-density polyethylene by mixed fungi composed of Alternaria sp. and Trametes sp. isolated from landfill sites. BMC Microbiol. 2024, 24, 321. [Google Scholar] [CrossRef]
- Ojha, N.; Pradhan, N.; Singh, S.; Barla, A.; Shrivastava, A.; Bose, S.; Rai, V. Evaluation of HDPE and LDPE degradation by fungus, implemented by statistical optimization. Sci. Rep. 2017, 7, 39515. [Google Scholar] [CrossRef]
- Khan, S.; Ali, S.A.; Ali, A.S. Biodegradation of low-density polyethylene (LDPE) by mesophilic fungus Penicillium citrinum isolated from soils of plastic waste dump yard, Bhopal, India. Environ. Technol. 2023, 44, 2300–2314. [Google Scholar] [CrossRef]
- Harrat, R.; Bourzama, G.; Burgaud, G.; Coton, E.; Bourezgui, A.; Soumati, B. Assessing the biodegradation of low-density polyethylene films by Candida tropicalis SLNEA04 and Rhodotorula mucilaginosa SLNEA05. Diversity 2024, 16, 759. [Google Scholar] [CrossRef]
- Awasthi, S.; Srivastava, N.; Singh, T.; Tiwary, D.; Mishra, P.K. Biodegradation of thermally treated low-density polyethylene by fungus Rhizopus oryzae NS 5. 3 Biotech 2017, 7, 73. [Google Scholar] [CrossRef] [PubMed]
- Sathiyabama, M.; Boomija, R.V.; Sathiyamoorthy, T.; Mathivanan, N.; Balaji, R. Mycodegradation of low-density polyethylene by Cladosporium sphaerospermum, isolated from platisphere. Sci. Rep. 2024, 14, 8351. [Google Scholar] [CrossRef] [PubMed]
- Gong, Z.; Jin, L.; Yu, X.; Wang, B.; Hu, S.; Ruan, H.; Sung, Y.-J.; Lee, H.-G.; Jin, F. Biodegradation of low-density polyethylene by the fungus Cladosporium sp. recovered from a landfill site. J. Fungi 2023, 9, 605. [Google Scholar] [CrossRef]
- Khruengsai, S.; Sripahco, T.; Pripdeevech, P. Microbial degradation of low-density polyethylene by Neopestalotiopsis phangngaensis. J. Gen. Appl. Microbiol. 2022, 68, 287–294. [Google Scholar] [CrossRef]
- Purohit, A.; Cochereau, B.; Sarkar, O.; Rova, U.; Christakopoulos, P.; Antonopoulou, I.; Villas-Boas, S.; Matsakas, L. Polyethylene biodegradation: A multifaceted approach. Biotecnol. Adv. 2025, 82, 108577. [Google Scholar] [CrossRef]
- Jin, J.; Arciszewski, J.; Auclair, K.; Jia, Z. Enzymatic polyethylene biorecycling: Confronting challenges and shaping the future. J. Hazard. Mater. 2023, 460, 132449. [Google Scholar] [CrossRef]
- Aguiar, M.I.S.; Sousa, A.F.; Teixeira, G.; Tavares, A.P.M.; Ferreira, A.M.; Coutinho, J.A.P. Enhancing plastic waste recycling: Evaluating the impact of additives on the enzymatic polymer degradation. Catal. Today 2024, 429, 114492. [Google Scholar] [CrossRef]
- Gao, H.; Chu, X.; Wang, Y.; Zhou, F.; Zhao, K.; Mu, Z.; Liu, Q. Media optimization for laccase production by Trichoderma harzianum ZF-2 using response surface methodology. J. Microbiol. Biotechnol. 2013, 23, 1757–1764. [Google Scholar] [CrossRef] [PubMed]
- Santacruz-Juárez, E.; Buendia-Corona, R.E.; Ramírez, R.E.; Sánchez, C. Fungal enzymes for the degradation of polyethylene: Molecular docking simulation and biodegradation pathway proposal. J. Hazard. Mater. 2021, 411, 125118. [Google Scholar] [CrossRef]
- Espino-Rammer, L.; Ribitsch, D.; Przylucka, A.; Marold, A.; Greimel, K.J.; Herrero Acero, E.; Guebitz, G.M.; Kubicek, C.P.; Druzhinina, I.S. Two novel class II hydrophobins from Trichoderma spp. stimulate enzymatic hydrolysis of poly(ethylene terephthalate) when expressed as fusion proteins. Appl. Environ. Microbiol. 2013, 79, 4230–4238. [Google Scholar] [CrossRef]
- Ribitsch, D.; Acero, E.H.; Przylucka, A.; Zitzenbacher, S.; Marold, A.; Gamerith, C.; Tscheließnig, R.; Jungbauer, A.; Rennhofer, H.; Lichtenegger, H.; et al. Enhanced cutinase-catalyzed hydrolysis of polyethylene terephthalate by covalent fusion to hydrophobins. Appl. Environ. Microbiol. 2015, 81, 3586–3592. [Google Scholar] [CrossRef] [PubMed]
- Dąbrowska, G.B.; Garstecka, Z.; Olewnik-Kruszkowska, E.; Szczepańska, G.; Ostrowski, M.; Mierek-Adamska, A. Comparative Study of structural changes of polylactide and poly(ethylene terephthalate) in the presence of Trichoderma viride. Int. J. Mol. Sci. 2021, 22, 3491. [Google Scholar] [CrossRef] [PubMed]
- Kleifeld, O.; Chet, I. Trichoderma harzianum—Interaction with plants and effect on growth response. Plant Soil 1992, 144, 267–272. [Google Scholar] [CrossRef]
- Accinelli, C.; Mencarelli, M.; Abbas, H.K.; Weaver, M.A. Extending the use of bioplastic granules for the application of Trichoderma biocontrol isolates in flori/horticulture and turfgrass. Acta Hortic. 2014, 1015, 79–88. [Google Scholar] [CrossRef]
- Tegariyanto, M.R.; Titah, H.S.; Pratikno, H. Biodegradation of polyethylene terephthalate (PET) plastics using a combination of Aspergillus niger and Trichoderma harzianum. IOP Conf. Ser. Earth Environ. Sci. 2024, 1414, 012028. [Google Scholar] [CrossRef]
- Rusetskaya, V.; Rózalska, S.; Słaba, M.; Bernat, P. Degradation ability of Trichoderma spp. in the presence of poly(butylene adipate-co-terephthalate) microparticles. Int. Biodeterior. Biodegrad. 2024, 193, 105829. [Google Scholar] [CrossRef]
- Jasińska, A.; Rózalska, S.; Rusetskaya, V.; Słaba, M.; Bernat, P. Microplastic-induced oxidative stress in metolachlor-degrading filamentous fungus Trichoderma harzianum. Int. J. Mol. Sci. 2022, 23, 12978. [Google Scholar] [CrossRef]
- Chaudhary, A.K.; Vijayakumar, R.P. Studies on biological degradation of polystyrene by pure fungal cultures. Environ. Dev. Sustain. 2019, 22, 4495–4508. [Google Scholar] [CrossRef]
- Fatima, S.; Iram, S. Identification of fungal pathotypes associated with skin disorders of Citrus reticulata Blanco through classical and molecular approach. Pak. J. Agric. Res. 2019, 32, 95–101. [Google Scholar] [CrossRef]
- Najam, M.; Javaid, S.; Iram, S.; Pasertsakoun, K.; Oláh, M.; Székács, A.; Aleksza, L. Microbial biodegradation of synthetic polyethylene and polyurethane polymers by pedospheric microbes: Towards sustainable environmental management. Polymers 2025, 17, 169. [Google Scholar] [CrossRef]
- Verma, N.; Gupta, S. Comparative assessment of polythene degradation by Trichoderma harzianum and Trichoderma viride. Aayushi Int. Interdisc. Res. J. 2018, 5, 63–69. [Google Scholar]
- Saeed, S.; Iqbal, A.; Deeba, F. Biodegradation study of polyethylene and PVC using naturally occurring plastic degrading microbes. Arch. Microbiol. 2022, 204, 497. [Google Scholar] [CrossRef] [PubMed]
- Lopez, L.F.; Morales-Fonseca, D. Evaluation of the biodegradation process of low-density polyethylene by Aspergillus brasiliensis in soil. Chem. Eng. Trans. 2023, 99, 397–402. [Google Scholar] [CrossRef]
- Singh, G.; Kaur, N.; Bhunia, H.; Bajpai, P.K.; Mandal, U.K. Degradation behaviors of linear low-density polyethylene and poly-(L-lactic acid) blends. J. Appl. Polym. Sci. 2012, 124, 1993–1998. [Google Scholar] [CrossRef]
- Mathur, G.; Prasad, R. Degradation of polyurethane by Aspergillus flavus (ITCC 6051) isolated from soil. Appl. Biochem. Biotechnol. 2012, 167, 1595–1602. [Google Scholar] [CrossRef]
- Corti, A.; Muniyasamy, S.; Vitali, M.; Imam, S.H.; Chiellini, E. Oxidation and biodegradation of polyethylene films containing pro-oxidant additives: Synergistic effects of sunlight exposure, thermal aging, and fungal biodegradation. Polym. Degrad. Stabil. 2010, 95, 1106–1114. [Google Scholar] [CrossRef]
- Montazer, Z.; Najafi, M.B.H.; Levin, D.B. Challenges with verifying microbial degradation of polyethylene. Polymers 2020, 12, 123. [Google Scholar] [CrossRef]
- Maity, S.; Banerjee, S.; Biswas, C.; Guchhait, R.; Chatterjee, A.; Pramanick, K. Functional interplay between plastic polymers and microbes: A comprehensive review. Biodegradation 2021, 32, 487–510. [Google Scholar] [CrossRef]
- Cameselle, C.; Bohlmann, J.; Núñez, M.; Lema, J.M. Oxalic acid production by Aspergillus niger. Part I: Influence of sucrose and milk whey as carbon source. Bioprocess Eng. 1998, 19, 247–252. [Google Scholar] [CrossRef]
- Safdar, A.; Ismail, F.; Imran, M. Biodegradation of synthetic plastics by the extracellular lipase of Aspergillus niger. Environ. Adv. 2024, 17, 100563. [Google Scholar] [CrossRef]
- Zhang, S.; Dang, L.; Li, W.; Zhang, Q.; Xiao, K.; Tong, T.; Liu, Q.; Ma, L.; Chen, N.; Zhang, L.; et al. Differential microbial degradation of cross-linked Polythene by Aspergillus niger in space and on the ground. Chem. Eng. J. 2025, 509, 161394. [Google Scholar] [CrossRef]
- Okal, E.J.; Zhou, J.; Wu, Y.; Zhong, T.; Tang, Y.; Sun, Z.; Xu, R.; Hu, Y.; Hu, Y.; Li, J.; et al. Unveiling fungal degradation pathways for polyurethane and polyethylene through enrichment cultures and metabolic analysis. Int. Biodeterior. Biodegr. 2025, 202, 106097. [Google Scholar] [CrossRef]
- Osman, M.; Satti, S.M.; Luqman, A.; Hasan, F.; Shah, Z.; Shah, A.A. Degradation of polyester polyurethane by Aspergillus sp. strain S45 isolated from soil. J. Polym. Environ. 2018, 26, 301–310. [Google Scholar] [CrossRef]
- Tiwari, N.; Santhiya, D.; Sharma, J.G. Degradation of polyethylene microplastics through microbial action by a soil isolate of Brevibacillus brevis. Polym. Degrad. Stab. 2023, 215, 110436. [Google Scholar] [CrossRef]
- Jeyakumar, D.; Chirsteen, J.; Doble, M. Synergistic effects of pretreatment and blending on fungi-mediated biodegradation of polypropylenes. Bioresour. Technol. 2013, 148, 78–85. [Google Scholar] [CrossRef]
- Cavello, I.A.; Cavalitto, S.F.; Hours, R.A. Biodegradation of a keratin waste and the concomitant production of detergent stable serine proteases from Paecilomyces lilacinus. Appl. Biochem. Biotechnol. 2012, 167, 945–958. [Google Scholar] [CrossRef]

| Medium | Fungal Strain | p-Value | Significance | |
|---|---|---|---|---|
| Aspergillus niger | Trichoderma harzianum | |||
| Liquid medium | 45.62 ± 0.21 | 36.01 ± 0.21 | p < 0.0001 | **** |
| Soil | 9.09 ± 0.08 | 10.00 ± 0.18 | p < 0.01 | ** |
Disclaimer/Publisher’s Note: The statements, opinions and data contained in all publications are solely those of the individual author(s) and contributor(s) and not of MDPI and/or the editor(s). MDPI and/or the editor(s) disclaim responsibility for any injury to people or property resulting from any ideas, methods, instructions or products referred to in the content. |
© 2025 by the authors. Licensee MDPI, Basel, Switzerland. This article is an open access article distributed under the terms and conditions of the Creative Commons Attribution (CC BY) license (https://creativecommons.org/licenses/by/4.0/).
Share and Cite
Ahmed, M.; Iram, S.; Tabassum, N.; Sajid, M.; Paseutsakoun, K.; Aleksza, L.; Székács, A. Biodegradation Efficacy of Aspergillus niger and Trichoderma harzianum on Low-Density Polyethylene. Polymers 2025, 17, 1303. https://doi.org/10.3390/polym17101303
Ahmed M, Iram S, Tabassum N, Sajid M, Paseutsakoun K, Aleksza L, Székács A. Biodegradation Efficacy of Aspergillus niger and Trichoderma harzianum on Low-Density Polyethylene. Polymers. 2025; 17(10):1303. https://doi.org/10.3390/polym17101303
Chicago/Turabian StyleAhmed, Momina, Shazia Iram, Noshabah Tabassum, Mahnoor Sajid, Kingkham Paseutsakoun, László Aleksza, and András Székács. 2025. "Biodegradation Efficacy of Aspergillus niger and Trichoderma harzianum on Low-Density Polyethylene" Polymers 17, no. 10: 1303. https://doi.org/10.3390/polym17101303
APA StyleAhmed, M., Iram, S., Tabassum, N., Sajid, M., Paseutsakoun, K., Aleksza, L., & Székács, A. (2025). Biodegradation Efficacy of Aspergillus niger and Trichoderma harzianum on Low-Density Polyethylene. Polymers, 17(10), 1303. https://doi.org/10.3390/polym17101303









